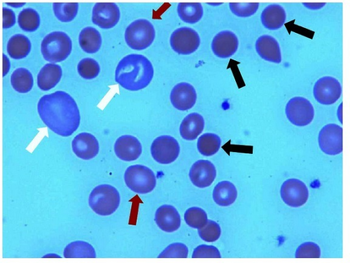
PMC3654623 CRIM.HEMATOLOGY2013-142865.001.png

Drug-Induced Autoimmune Hemolytic Anemia
 From Mdwiki
From Mdwiki | Drug-induced autoimmune heamolytic anemia | |
|---|---|
| |
| Ibuprofen-induced hemolytic anemia-Peripheral blood smear shows microspherocytes arrows, polychromasia | |
| Specialty | Hematology |
Drug-induced autoimmune hemolytic anemia is a form of hemolytic anemia.
In some cases, a drug can cause the immune system to mistakenly think the body's own red blood cells are dangerous, foreign substances. Antibodies then develop against the red blood cells. The antibodies attach to red blood cells and cause them to break down too early. It is known that more than 150 drugs can cause this type of hemolytic anemia.[1] The list includes :
- Cephalosporins (a class of antibiotics)
- Dapsone
- Levodopa
- Levofloxacin
- Methyldopa
- Nitrofurantoin
- Nonsteroidal anti-inflammatory drugs (NSAIDs) - among them, the commonly used Diclofenac and Ibuprofen
- Phenazopyridine (pyridium)
- Quinidine[2]
Penicillin in high doses can induce immune mediated hemolysis[3] via the hapten mechanism in which antibodies are targeted against the combination of penicillin in association with red blood cells. Complement is activated by the attached antibody leading to the removal of red blood cells by the spleen.[citation needed]
The drug itself can be targeted by the immune system, e.g. by IgE in a Type I hypersensitivity reaction to penicillin, rarely leading to anaphylaxis.[citation needed]
See also[edit | edit source]
References[edit | edit source]
- ↑ Barcellini, Wilma (2015-10-01). "Immune Hemolysis: Diagnosis and Treatment Recommendations". Seminars in Hematology. Anemia in Clinical Practice. 52 (4): 304–312. doi:10.1053/j.seminhematol.2015.05.001. ISSN 0037-1963. PMID 26404442.
- ↑ MedlinePlus Encyclopedia: Drug-induced immune hemolytic anemia
- ↑ Stroncek, David; Procter, Jo L.; Johnson, Judy (2000). "Drug-induced hemolysis: Cefotetan-dependent hemolytic anemia mimicking an acute intravascular immune transfusion reaction". American Journal of Hematology. 64 (1): 67–70. doi:10.1002/(SICI)1096-8652(200005)64:1<67::AID-AJH12>3.0.CO;2-Z. PMID 10815791.
External links[edit | edit source]
| Classification |
|---|
Categories: [Acquired hemolytic anemia] [Drug-induced diseases]
↧ Download as ZWI file | Last modified: 10/25/2023 00:56:44 | 2 views
☰ Source: https://mdwiki.org/wiki/Drug-induced_autoimmune_hemolytic_anemia | License: CC BY-SA 3.0
 ZWI signed:
ZWI signed: KSF
KSF